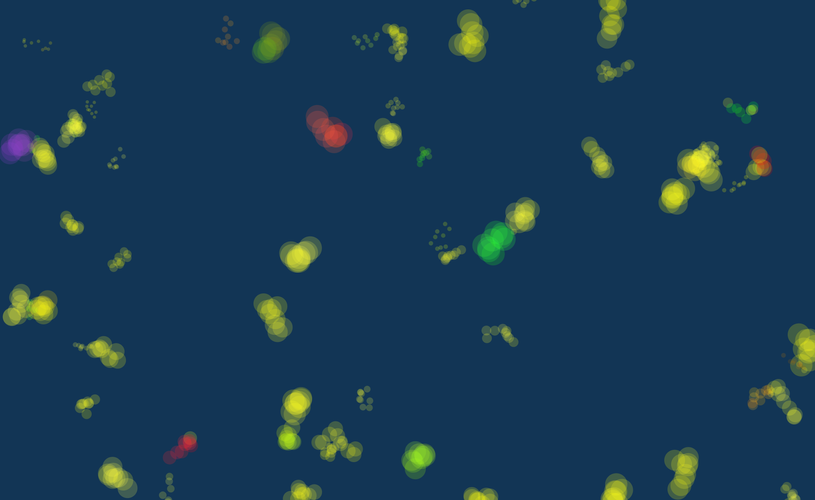

XSHELL
PAPER SHELL MADE OF CELL UNIT
ELECTIVE COURSE, FALL '19, CORNELL UNIVERSITY
IN COLLABORATION WITH YU SUN, MENGYI YAN, AND JUNSIK OH
XSHELL
PAPER SHELL MADE OF CELL UNIT
ELECTIVE COURSE, FALL '19, CORNELL UNIVERSITY
IN COLLABORATION WITH YU SUN, MENGYI YAN, AND JUNSIK OH
This project explores the simplest way of constructing a doubly-curved shell structure - by setting the fabrication method based on planar manufacture, which can be achieved by CNC Routers or laser machines and using sheet materials like chipboard. The cellular unit was mapped and unrolled to planar folding and cutting lines, fabricated through tens of recycling chipboards within 2mm thickness. The whole fabricating process including cutting, folding, and assembling took only 5 days and 3 group members to complete the construction of this human-scale installation on the 3rd floor of Sibley Hall.
This project explores the simplest way of constructing a doubly-curved shell structure - by setting the fabrication method based on planar manufacture, which can be achieved by CNC Routers or laser machines and using sheet materials like chipboard. The cellular unit was mapped and unrolled to planar folding and cutting lines, fabricated through tens of recycling chipboards within 2mm thickness. The whole fabricating process including cutting, folding, and assembling took only 5 days and 3 group members to complete the construction of this human-scale installation on the 3rd floor of Sibley Hall.

COMPUTATION DESIGN
This page keeps the record of some design pieces created by codes and implements several classic or innovative algorithms. They are all small projects, but through them, I improve my skills as a design coder and mature the way of computation thinking.
HY-CY MATTERS
WORKSHOP, SUMMER '20, DIGITALFUTURES 2020
SOFTWARE/LANGUAGE: HOUDINI / C#
KEYWORDS: DIFFERENTIAL GROWTH, BIOMIMICAL SKELETON
This project is designed based on the idea of the biological integration between two different material systems: Soft muscles and hard skeleton. However, the norm of the topological structure of the skeleton on the inside and muscle on the outside is being reversed; in the proposal, the skeleton is the exposed structure that creates a medium where the muscles grow and penetrate through it at certain areas to enhance the performance of a person.
The design implements the notion of personification with an aesthetically pleasing design approach. It will be using 3D Printing as a fabrication tool to enhance lifestyle while being affordable, flexible, and creative.
MESH SCULPTURE
ELECTIVE COURSE, FALL '20, CORNELL UNIVERSITY
SOFTWARE/LANGUAGE: RHINOCEROS, GRASSHOPPER / C#
KEYWORDS: VECTOR FIELD, MINKOWSKI DISTANCE, MODULO FUNCTION
The aim of this assignment was to design a mesh sculpture by applying three different operations: {α} a shape modifier driven by a vector field, {β} a face culling scheme and {γ} a face creation scheme.
To achieve the requirement, I build a complex vector field that consists of both curl and diverge charges, creating a combination of spinning and attracting effect. Then I use the modulo of custom distance functions, i.e. Minkowski distance, to cull faces in the mesh for stripping effect. Finally, I offset faces on the mesh based on the curl noise, making a furry and wavy skin on top of the modified mesh.
PROCEDURAL LANDSCAPE
ELECTIVE COURSE, FALL '20, CORNELL UNIVERSITY
SOFTWARE / LANGUAGE: RHINOCEROS, GRASSHOPPER / C#
KEYWORDS: MEDIAL AXES TRANSFORM (MAT), GRAPH TRAVERSAL, DISTANCE FIELD
This assignment creates a procedural landscape based on only one input: the boundary condition. The main algorithm I applied here is Medial Axes Transform, which uses the inherent property of a closed curve to create a skeleton network and thus generates a graph, which can embed height, curvature, and slope property. By controlling these properties, the customized distance function of this graph can create the topography. Finally, landscape element like trees is adaptively distributed to the topography based on the curvature information, where the plants are distributed more densely in steep areas while only distributed in the edges of flat area.
SPONGE TOWERS
COLLABORATIVE WORK, SUMMER '20
SOFTWARE / LANGUAGE: HOUDINI / C#
KEYWORDS: SPONGE STRUCTURE, BIOMIMICAL DESIGN
This design mimics the behavior of the sponge, the first animal species to branch off the evolutionary tree from the common ancestor of all animals. An algorithm based on constructive solid geometry was developed to simulate the entwined and porous characteristic of the sponge, generating a woven skeleton and porous facade, echoing the corresponding biological property, inviting soft air circulation, and proper temperature adaption in the atrium space.
ILLUSTRATING TRACES
ELECTIVE COURSE, SUMMER '19, CORNELL UNIVERSITY
SOFTWARE / LANGUAGE: PROCESSING / JAVA
KEYWORDS: PARTICLE SYSTEM
These pieces of artwork are a series of procedural drawings created in Processing. By using a particle-based system, I can simulate and keep the traces of different particles that move as a swarm system. As the particles are following specific rules and influence each other, the results are not predictable but the trend of general color distribution and proportion can be controlled by those input parameters of the starting particles.